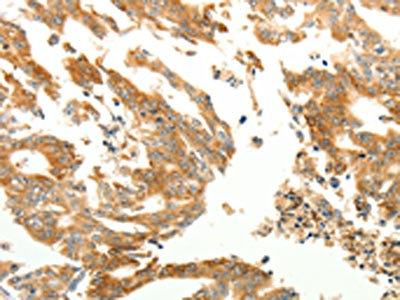

RARRES1 Antibody
-
中文名稱:RARRES1兔多克隆抗體
-
貨號:CSB-PA843377
-
規格:¥1100
-
圖片:
-
The image on the left is immunohistochemistry of paraffin-embedded Human colon cancer tissue using CSB-PA843377(RARRES1 Antibody) at dilution 1/60, on the right is treated with synthetic peptide. (Original magnification: ×200)
-
The image on the left is immunohistochemistry of paraffin-embedded Human gastric cancer tissue using CSB-PA843377(RARRES1 Antibody) at dilution 1/60, on the right is treated with synthetic peptide. (Original magnification: ×200)
-
Gel: 10+15%SDS-PAGE, Lysate: 50 μg, Lane: Human liver cancer tissue, Primary antibody: CSB-PA843377(RARRES1 Antibody) at dilution 1/300, Secondary antibody: Goat anti rabbit IgG at 1/8000 dilution, Exposure time: 40 seconds
-
-
其他:
產品詳情
-
Uniprot No.:
-
基因名:RARRES1
-
別名:RARRES1; PEIG1; TIG1; Retinoic acid receptor responder protein 1; Phorbol ester-induced gene 1 protein; PERG-1; RAR-responsive protein TIG1; Tazarotene-induced gene 1 protein
-
宿主:Rabbit
-
反應種屬:Human
-
免疫原:Synthetic peptide of Human RARRES1
-
免疫原種屬:Homo sapiens (Human)
-
標記方式:Non-conjugated
-
抗體亞型:IgG
-
純化方式:Antigen affinity purification
-
濃度:It differs from different batches. Please contact us to confirm it.
-
保存緩沖液:-20°C, pH7.4 PBS, 0.05% NaN3, 40% Glycerol
-
產品提供形式:Liquid
-
應用范圍:ELISA,WB,IHC
-
推薦稀釋比:
Application Recommended Dilution ELISA 1:2000-1:5000 WB 1:500-1:2000 IHC 1:100-1:300 -
Protocols:
-
儲存條件:Upon receipt, store at -20°C or -80°C. Avoid repeated freeze.
-
貨期:Basically, we can dispatch the products out in 1-3 working days after receiving your orders. Delivery time maybe differs from different purchasing way or location, please kindly consult your local distributors for specific delivery time.
-
用途:For Research Use Only. Not for use in diagnostic or therapeutic procedures.
相關產品
靶點詳情
-
功能:Inhibitor of the cytoplasmic carboxypeptidase AGBL2, may regulate the alpha-tubulin tyrosination cycle.
-
基因功能參考文獻:
- TIG1 interacted with DNAJC8 in the cytosol, and this interaction completely blocked DNAJC8-mediated PKM2 translocation and inhibited glucose uptake. Furthermore, increased glycose uptake was observed in cells in which TIG1 was silenced. PMID: 29902837
- Data demonstrated that RARRES1 expression is lost in choriocarcinoma tumors due to promotor hypermethylation. Also, further results hypothesized that RARRES1 might be a negative regulator of EMT through induction of contact inhibition. PMID: 29169400
- Data show that retinoic acid receptor responder 1 (RARRES1) expression is subtype-dependent and regulated by DNA methylation and the expression of aldehyde dehydrogenase 1A3 (ALDH1A3). PMID: 27286452
- Data suggest that Retinoic Acid Receptor Responder (RARRES1)/ Tazarotene-induced gene-1 (TIG-1) may serve as a target for therapeutic intervention both in cancer and in angiogenesis-related disorders. PMID: 28678839
- Authors found that transmembrane protein 192 (TMEM192) interacted with TIG1. Authors also found that both TIG1A and TIG1B isoforms interacted and co-localized with TMEM192 in HtTA cervical cancer cells. The expression of TIG1 induced the expression of autophagy-related proteins. PMID: 27989102
- All-trans retinoic acid modulated secretion of RARRES1 in a dose dependent manner. PMID: 22942771
- our data suggested that epigenetic silencing of TIG1 gene expression by promoter hypermethylation may play an important role in hepatocellular carcinoma . PMID: 24006221
- High TIG1 expression is associated with inflammatory breast cancer through activation of Axl kinase. PMID: 24014597
- Analysis of a standard liver fibrosis model (CCl(4)) demonstrated an early induction of RARRES1 mRNA and protein expression. PMID: 22669512
- genotype-associated hypermethylation of the ETS-family target gene RARRES1 influences methylation at its neighbor gene LXN and could be useful as a prognostic biomarker. PMID: 22573467
- Knocking-down CTCF expression hampered RARRES1 expression. PMID: 22615834
- TIG1 suppressed PGE2-stimulated Wnt and cAMP signaling pathways in colon cancer cells through GRK5. PMID: 22126303
- GRK5 mediates cell growth suppression by TIG1A. Thus, TIG1 may participate in the downregulation of G-protein coupled signaling by upregulating GRK5 expression. PMID: 21575264
- The results of this study suggested that short RAI1 alleles might be releated to schizophreina disease. PMID: 21168224
- RARRES1, its interacting partners AGBL2, Eg5/KIF11, another EEY-bearing protein (EB1), and the microtubule tyrosination cycle are important in tumorigenesis. PMID: 21303978
- Silencing of TIG1 promoter by hypermethylation is common in human cancers and may contribute to the loss of retinoic acid responsiveness in some neoplastic cells. PMID: 15059893
- Hypermethylation of tazarotene-induced gene 1 is associated with gastric carcinogenesis PMID: 16134180
- TIG1 overexpression in SASC inhibited their differentiation into osteocytes and the expression of osteocalcin PMID: 19250291
- Findings suggest that TIG1 may play a role in cellular proliferation and invasion in NPC cells and that its function may be dependent on the EBV status. PMID: 19737656
- TIG1 undergoes frequent epigenetic inactivation due to aberrant DNA hypermethylation in gastric cancers. PMID: 19806788
顯示更多
收起更多
-
亞細胞定位:Membrane; Single-pass type III membrane protein.
-
蛋白家族:Protease inhibitor I47 (latexin) family
-
數據庫鏈接:
Most popular with customers
-
-
YWHAB Recombinant Monoclonal Antibody
Applications: ELISA, WB, IHC, IF, FC
Species Reactivity: Human, Mouse, Rat
-
Phospho-YAP1 (S127) Recombinant Monoclonal Antibody
Applications: ELISA, WB, IHC
Species Reactivity: Human
-
-
-
-
-